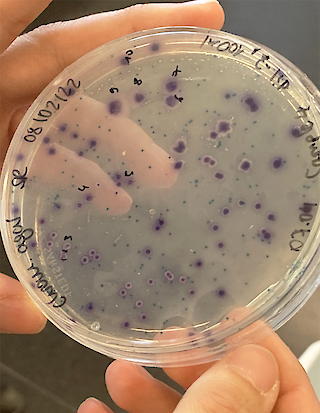
Dauerpräparat

Deine unsichtbaren Mitbewohner:innen
steven.kaiser@zhdk.ch
[DE]
Micromates ist eine Serie textiler Produkte, die die alltägliche Symbiose zwischen Mensch und Mikrobiom würdigt. Die Pilze, Parasiten, Bakterien und Viren, die zum Mikrobiom zählen, sind mit blossem Auge für uns meist nicht zu erkennen. Micromates platziert Darstellungen von ihnen auf einem Duschvorhang, einem Handtuch und Badezimmerteppich. Indem die Kollektion mit den Grenzen unserer visuellen Wahrnehmung spielt, ermöglicht sie einen neuen Blick auf unsere direkte Umgebung und die gesamte Umwelt.
Micromates nimmt Bezug auf den Gedanken des Post-Anthropozentrismus. Die Produkte reagieren auf das wachsende Bewusstsein, dass der Mensch zusammen mit und nicht hierarchisch über den Organismen lebt. Dazu zählen auch die unsichtbaren Wesen, welche in und bei uns leben.
Die Darstellungen haben ihren Ursprung in mikroskopischen Bildern, welche als Ausgangslage für ein Pattern-Archiv dienen. Die Muster formen sich zu Figuren. Deren Farbigkeit ist frei gewählt, welches auch im biologischen Bereich so üblich ist. Grössenverhältnisse werden skaliert, um den Micromates einen ansprechenden Ausdruck zu verleihen. Nimm deine kleinen Mitbewohner:innen bei der Hand und lass dich von ihrem bis anhin kaum beachteten Lebensraum verzaubern.
[EN]
Micromates is a series of textile products that pays tribute to the everyday symbiosis between humans and the microbiome. The fungi, parasites, bacteria and viruses that make up the microbiome are usually invisible to the naked eye. Here, representations of them are placed on common objects such as a shower curtain, towel and bathroom rug. By playing with the limitations of our visual perception, the collection allows us to take a new look at our immediate surroundings and the environment as a whole.
Micromates makes reference to the idea of post-anthropocentrism, and the products respond to the growing awareness that humans live together with, rather than hierarchically above, organisms. This includes the invisible beings that live both in and with us.
The representations originate in microscopic images which serve as the starting point for a pattern archive. The patterns transform themselves into figures. Their colour is chosen freely, which is also common in the biological field. Size ratios are scaled to give the ‘micromates’ an appealing expression. Take your little buddies by the hand and let yourself be enchanted by their barely noticeable habitat.